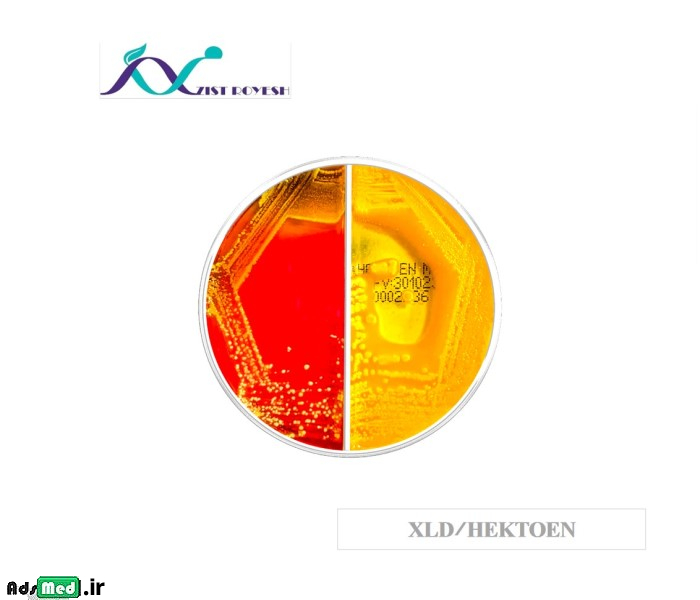
محیط کشت دو قسمتی XLD/هکتون ۸cm زیست رویش
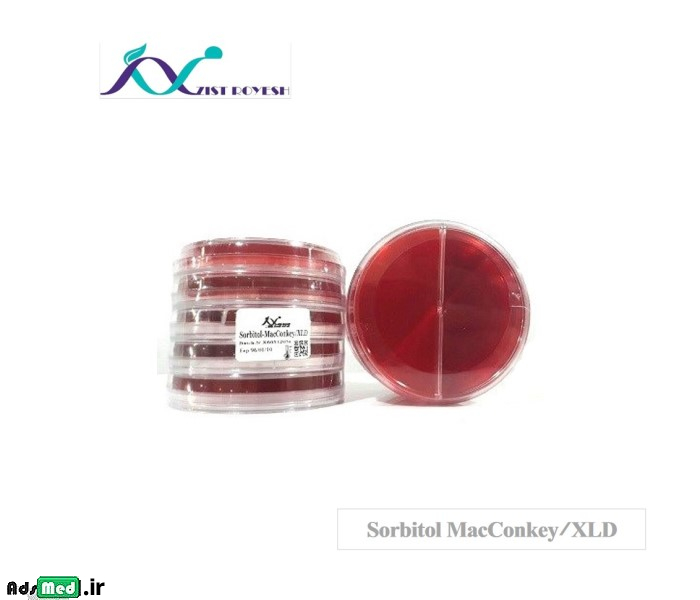
محیط کشت دو قسمتی XLD/سوربیتول ۸cm زیست رویش

- دی۱۴۰۴
- 4403 بازدید
- دسترسی آسان و سریع به کالاها و خدمات پزشکی و آزمایشگاهی در سرتاسر ایران!
- تمام موقعیت ها :




- تهران
- تهران و کرج
- اصفهان
- خراسان رضوی
- فارس
- مازندران
- آذربایجان شرقی
- البرز
- خوزستان
- کرمانشاه
- کرمان
- آذربایجان غربی
- مرکزی
- اردبیل
- بوشهر
- هرمزگان
- گیلان
- یزد
- گلستان
- ایلام
- خراسان شمالی
- خراسان جنوبی
- سیستان و بلوچستان
- لرستان
- سمنان
- کردستان
- زنجان
- قم
- قزوین
- همدان
- غرب ایران
- چهارمحال و بختیاری
- کهگیلویه وبویراحمد
- جنوب ایران
- شمال ایران
- شرق ایران
- شمال تهران
- جنوب تهران
- شرق تهران
- غرب تهران
- مرکز تهران